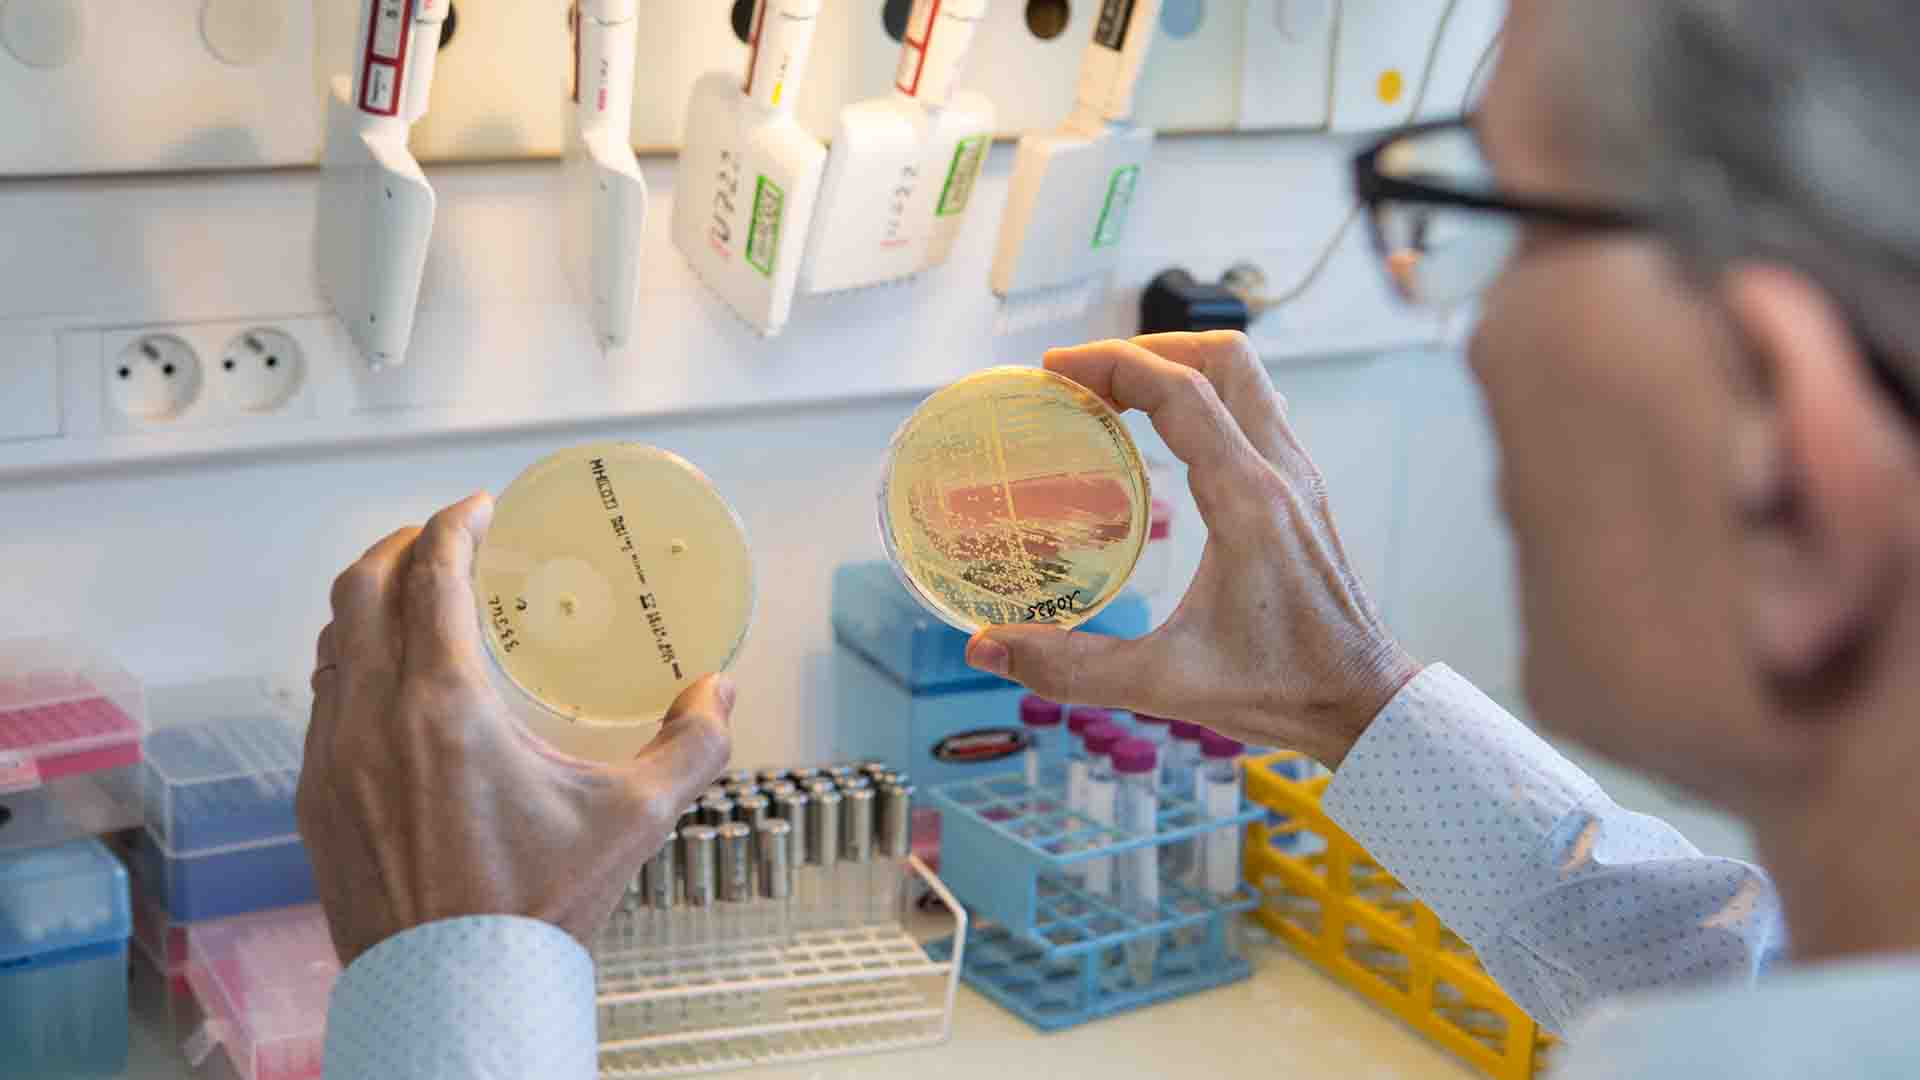

Les résultats de l’appel à projets Fédérations hospitalo-universitaires viennent d’être communiqués. Découvrez les lauréats.
Chaque FHU est constituée sur un thème médical défini, au sein des périmètres hospitalo-universitaires (dont au moins une université, un groupe hospitalier de l’AP-HP et un laboratoire d’organisme national de recherche).
Les chercheurs, enseignants-chercheurs et personnels hospitaliers de ces FHU ont un niveau d’excellence qui les positionne comme références internationales sur les thèmes médicaux définis.
Parmi les 21 projets FHU retenus en Ile-de-France, plus de la moitié sont portés par Université Paris Cité.
Découvrez les projets lauréats :
NeuroVasc
« University Hospital Federation – FHU NeuroVasc to improve clinical care, treatment and research in neurovascular disorders » / « Fédération Hospitalo-universitaire – FHU NeuroVasc pour améliorer les soins cliniques, le traitement et la recherche dans les troubles neurovasculaires »
Projet porté par le Pr Hugues CHABRIAT , hôpital Lariboisière AP-HP. Nord – Université Paris Cité, Inserm U1141
CHILD
« Reducing mortality and severe morbidity in the first 3 years of life » / « Réduire la mortalité et la morbidité sévère au cours des 3 premières années de vie »
Projet porté par le Pr Martin CHALUMEAU, hôpital Necker-Enfants malades AP-HP. Centre – Université Paris Cité, Inserm UMR 1153
DDS-ParisNet
« Dental Diseases Network in Paris » / « Réseau des maladies dentaires à Paris »
Projet porté par la Pr Catherine CHAUSSAIN , hôpital Bretonneau, AP-HP. Nord – Université Paris Cité et la Pr Ariane BERDAL , hôpital Rotschild AP-HP. Sorbonne Université, Université Paris Cité, Inserm UMRS 1138
PROTHEE
« Prosthetic joint infections: innovative strategies to overcome a medico-surgical challenge »/ « Infections articulaires prothétiques: stratégies innovantes pour surmonter un défi médico-chirurgical »
Projet porté par la Pr Anne-Claude CREMIEUX, hôpital Saint-Louis AP-HP . Nord – Université Paris Cité, Inserm UMR 1173
I2-D2
« Early Identification of Individual Trajectories in NeuroDevelopmentalDisorders » / « Identification précoce des trajectoires individuelles dans les troubles neuro-développementaux »
Projet porté par le Pr Pierre GRESSENS, hôpital Robert-Debré AP-HP. Nord – Université Paris Cité, Inserm UMR 1141
PREVENT_HF
« Predict & Prevent Heart Failure in Young Subjects » / « Prédire et prévenir l’insuffisance cardiaque chez les jeunes patients »
Projet porté par le Pr Jean-Sébastien HULOT, hôpital européen Georges-Pompidou AP-HP. Centre – Université Paris Cité, Inserm UMRS 970
APOLLO
« Personalized medicine in chronic cardiovascular, respiratory, renal diseases and organ transplantation » / « Médecine personnalisée en maladies cardiovasculaires chroniques, respiratoires, rénales et transplantation d’organes »
Projet porté par le Pr Carmen LEFAUCHEUR, hôpital Saint-Louis AP-HP. Nord – Université Paris Cité, Université Paris Cité, Inserm U970
PROMICE
« PRecision Medicine for a cOMprehensIve CarE of Critically ill patients », « Médicament de précision pour des soins complets aux patients gravement malades »
Projet porté par le Pr MEBAZAA Alexandre, hôpital Lariboisière AP-HP. Nord – Université Paris Cité, Université Paris Cité, Inserm U942
MOSAIC
« Multiscale Optimized Strategy for Artificial Intelligence-based Imaging Biomarkers in Digestive Cancer Applications in hepatocellular carcinomas and neuro-endocrine tumors », « Stratégie optimisée à plusieurs échelles pour les biomarqueurs d’imagerie basés sur l’intelligence artificielle dans les applications du cancer digestif, dans les carcinomes hépatocellulaires et les tumeurs neuroendocrines »
Projet porté par la Pr Valérie PARADIS, hôpital Beaujon AP-HP. Nord – Université Paris Cité, Université Paris Cité, Inserm UMR 1149
PREMA
« Fighting Prematurity » / « Lutter contre la prématurité »
Projet porté par le Pr Vassilis TSATSARIS, hôpital Cochin AP-HP. Centre – Université Paris Cité, Inserm UMR-S 1139
NOR-SUD NOR-SUD
« Network of Research in Substance Use Disorders » / « Réseau de recherche sur les troubles liés à la toxicomanie »
Projet porté par le Pr Florence VORSPAN , hôpital Fernand-Widal AP-HP. Nord – Université Paris Cité, Inserm U 1144
Qu’est-ce qu’une FHU ?
La création des Fédérations Hospitalières Universitaires est consécutive à l’évaluation des Départements Hospitalo-Universitaires (DHU) par le HCERES et à son bilan positif. Il a donc été décidé de renouveler ce dispositif et de le rebaptiser Fédérations Hospitalo-Universitaires (FHU) afin de mieux traduire la volonté de fédérer les équipes de recherche.
Quel est l’objectif des FHU ?
Il s’agit de créer une synergie forte entre l’hôpital, les universités et les organismes de recherche pour améliorer la recherche médicale et la qualité des soins mais aussi pour contribuer au rayonnement rapide de l’innovation et à une meilleure visibilité internationale.
Comment les projets ont-ils été sélectionnés ?
Sur les 47 projets initialement présentés, 29 ont été sélectionnés pour l’étape des auditions. Le jury international présidé par le Pr Kim Fox de l’Imperial College et les partenaires de cet appel à projets ont décidé de labelliser et financer 21 FHU pour une durée de cinq ans. Le jury composé de personnalités exerçant leur activité en région ou à l’étranger a souligné l’excellence des projets présentés.
À lire aussi

Prix Irène Joliot-Curie 2024 : Marie Verbanck récompensée
Créé en 2001 par le Ministère de l’Enseignement supérieur et de la Recherche, le prix Irène Joliot-Curie récompense chaque année des femmes qui se distinguent par la qualité de leurs recherches dans l’univers des sciences, de la recherche et de la technologie....

Les bactériophages, vers une alternative ciblée aux antibiotiques
Avec l’essor des antibiotiques dans les années 1930, la phagothérapie a été abandonnée. Aujourd’hui, la montée de l’antibiorésistance rend le traitement des infections bactériennes de plus en plus difficile et la phagothérapie suscite à nouveau l’intérêt des médecins...

26 Highly Cited Researchers 2024 : 26 citations pour l’université Paris Cité
Avec 26 mentions en première affiliation, l’université Paris Cité assoit sa position qui confirme l’influence de sa communauté de recherche au niveau mondial. Université Paris Cité félicite ces 26 highly cited researchers. Lire la suite 26 Highly Cited Researchers 2024 : 26 citations pour l’université Paris Cité
![[Retour sur la conférence La Guilde] L’Intelligence artificielle dans l’enseignement supérieur et la recherche : débats et perspectives](https://wordpress-test.app.u-pariscite.fr/wp-content/uploads/2024/11/Allassonniere_Loupy_1920-1-1080x675.jpg)
[Retour sur la conférence La Guilde] L’Intelligence artificielle dans l’enseignement supérieur et la recherche : débats et perspectives
Le 6 novembre 2024, l’université Paris Cité et l’Université PSL ont réuni les communautés des universités membres du réseau La Guilde lors d’un événement consacré à l’intelligence artificielle et son impact sur les universités, au sein du PariSanté Campus. Stéphanie...
